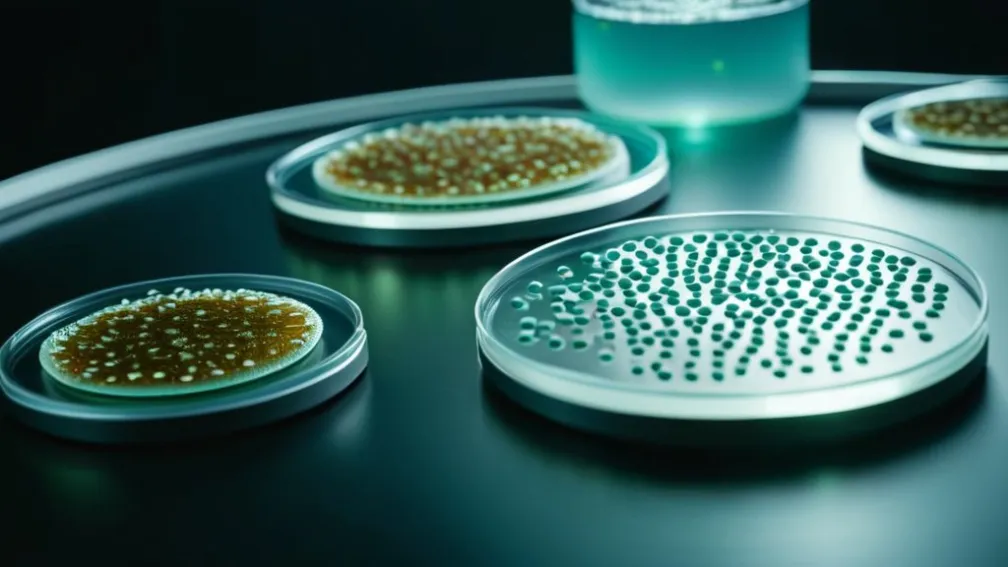
Formulele pentru bebeluși ByHeart rechemate de pe piață, dar încă se găsesc în magazine, pe măsură ce cazurile de botulism cresc

În câteva cuvinte
Chiar și după rechemarea formulei pentru bebeluși ByHeart din cauza contaminării bacteriene care a provocat botulism infantil, produsul este încă disponibil în unele magazine din SUA.
Pe măsură ce numărul cazurilor de botulism potențial mortal la bebelușii care au consumat formula ByHeart continuă să crească, oficialii de stat declară că încă găsesc produsul pe rafturile unor magazine.
Între timp, compania a raportat miercuri seara târziu că testele de laborator au confirmat că unele mostre de formulă au fost contaminate cu tipul de bacterii care au îmbolnăvit peste 30 de bebeluși în timpul focarului.
Testele efectuate de un laborator independent de siguranță alimentară au descoperit Clostridium botulinum, o bacterie care produce toxine ce pot duce la boli potențial mortale la bebelușii sub 1 an, a declarat compania pe site-ul său web. Oficialii ByHeart au menționat că au notificat Administrația pentru Alimente și Medicamente din SUA (FDA) cu privire la constatări, dar nu au specificat câte mostre au fost testate sau câte au fost pozitive.
„Lucrăm pentru a investiga faptele, a efectua teste continue pentru a identifica sursa și a ne asigura că acest lucru nu se va mai întâmpla familiilor”, a declarat ByHeart pe site-ul său web.
FDA nu a răspuns imediat la întrebările privind constatările.
Rezultatele de laborator apar în contextul în care investigatorii din cel puțin trei state au descoperit că formula ByHeart este încă de vânzare, chiar și după ce compania din New York a retras toate produsele la nivel național, au declarat oficialii.
Cel puțin 31 de bebeluși din 15 state care au consumat formula ByHeart au fost spitalizați și tratați pentru botulism infantil din luna august. Vârsta lor variază de la aproximativ 2 săptămâni la aproximativ 6 luni, cel mai recent caz fiind raportat pe 13 noiembrie.
Nu au fost raportate decese.
În Oregon, nouă din peste 150 de magazine verificate încă aveau formula pe rafturi săptămâna aceasta, a declarat un oficial agricol de stat. În Minnesota, investigatorii au efectuat 119 controale între 13 și 17 noiembrie și au retras produse rechemate de la vânzare în patru locații, a declarat un oficial al departamentului agricol. Un oficial de sănătate din Arizona a declarat, de asemenea, că a găsit produsul disponibil.
Întreprinderile și consumatorii ar trebui să rămână în alertă, au declarat oficialii din Minnesota într-o declarație. „Niciun produs afectat nu ar trebui vândut sau consumat”, au scris aceștia.
Investigatorii de la Administrația pentru Alimente și Medicamente din SUA au efectuat inspecții la fabricile ByHeart din Allerton, Iowa, și Portland, Oregon. Nu au fost raportate rezultate ale inspecțiilor.
Oficialii din California au confirmat anterior germenul care poate duce la îmbolnăvire într-o cutie deschisă de formulă ByHeart dată unui bebeluș care s-a îmbolnăvit.
Botulismul, care poate provoca paralizie și moarte, este cauzat de un tip de bacterii care formează spori ce germinează în intestinul bebelușului și produc o toxină.
Simptomele pot dura până la 30 de zile pentru a se dezvolta și includ constipația, alimentația slabă, plânsul slab, pleoapele căzute sau o expresie facială plată. Bebelușii pot dezvolta slăbiciune în membre și cap și pot părea „moi”. Pot avea dificultăți la înghițire sau la respirație.
ByHeart producea aproximativ 200.000 de cutii de formulă pe lună. Era vândută online sau în magazinele de retail precum Target și Walmart. Un purtător de cuvânt al Walmart a declarat că firma a emis rapid o restricție care a împiedicat vânzarea formulei, a retras produsul din magazine și a notificat consumatorii care l-au cumpărat. Clienții pot vizita orice magazin pentru a primi o rambursare pentru formula, care se vindea la aproximativ 42 de dolari pe cutie.
Oficialii federali și de stat din domeniul sănătății sunt îngrijorați că unii părinți și îngrijitori ar putea încă avea produse ByHeart în casele lor. Ei sfătuiesc consumatorii să nu mai folosească produsul — inclusiv formula în cutii și orice bețișoare individuale. De asemenea, sugerează să-l marcheze cu „NU UTILIZAȚI” și să-l păstreze cel puțin o lună în cazul în care un bebeluș dezvoltă simptome. În acest caz, formula ar trebui testată.
Departamentul de Sănătate din California operează Programul de Tratament și Prevenire a Botulismului Infantil, care monitorizează cazurile și distribuie tratamentul pentru boală. Oficialii de acolo au lansat o linie telefonică publică la 833-398-2022, la care răspund oficiali din sănătate între orele 7 a.m. și 11 p.m., ora standard a Pacificului.
Noua linie telefonică a fost creată după ce sute de apeluri de la părinți și îngrijitori au inundat o altă linie telefonică existentă de mult timp, destinată medicilor pentru a discuta cazurile suspecte de botulism infantil.





